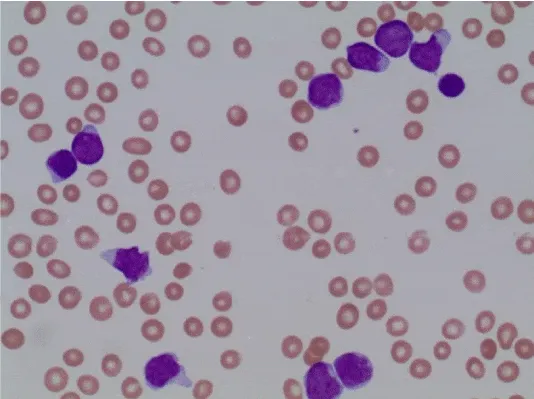
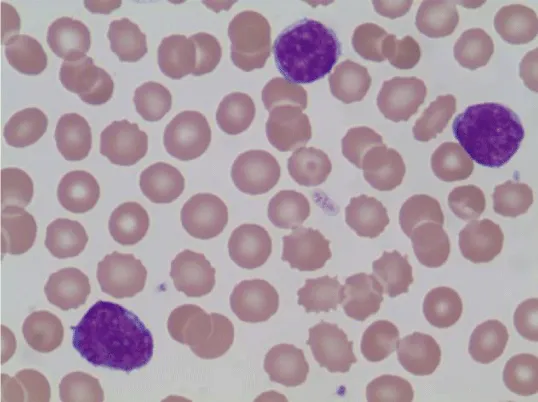

Global Journal of Cancer Therapy
Gamma-Delta T Cell Acute Lymphoblastic Leukemia: A Single-Center Experience
1Division of Hematology Oncology, University of Alabama at Birmingham
2Dept of Bonemarrow Transplantation, University of Alabama at Birmingham
3Dept of Hematopathology, University of Alabama at Birmingham
Author and article information
Cite this as
Donnellan W, Mineishi S, Wicker J, Paluri R (2016) Gamma-Delta T Cell Acute Lymphoblastic Leukemia: A Single-Center Experience. Glob J Cancer Ther. 2016; 2(1): 26-29. Available from: 10.17352/gjct.000010
Copyright License
© 2016 Donnellan W, et al. This is an open-access article distributed under the terms of the Creative Commons Attribution License, which permits unrestricted use, distribution, and reproduction in any medium, provided the original author and source are credited.Gamma-delta (γδ) T cell neoplasms are a rare disease entity characterized by an aggressive clinical course [1,2]. The management of these neoplasms associated with high incidence of induction failures and poor clinical outcomes [3]. Here we present two cases of gamma-delta T cell acute lymphoblastic leukemia (γδ T-ALL) successfully treated with chemotherapy and allogeneic stem cell transplant at our institution. We also review the literature and summarize what is known about this disease. In our experience, induction chemotherapy followed by allogeneic stem cell transplantation has been an effective strategy in producing durable remissions.
Two different antigen receptors have been described for T lymphocytes. Both have two polypeptide chains that recognize antigen and participate in T cell effector function [4,5]. The more common alpha beta T cell receptor (TCR) is present on the majority of peripheral blood T lymphocytes. In 1986 a second TCR, the gamma-delta receptor, was first described [6,7]. This receptor has subsequently been identified on approximately 1-5% of circulating blood T lymphocytes [8,9]. Immunophenotypically, the vast majority of gamma-delta T lymphocytes are negative for both CD4 and CD8 [10]. This is in contrast to alpha-beta T lymphocytes which are typically CD4+CD8- or CD4-CD8+ [11].
Gamma delta T cell malignancies are rare and comprise a minority of precursor T-cell lymphoblastic leukemias (γδ T-ALL), T-cell granular lymphocytic leukemias (T-LGL) and peripheral T cell lymphomas (PTCL) [12]. Specifically in regards to ALL, 2 – 14 % expresses the gamma delta TCR [13,14]. The γδ T-ALL/LBL, T-LGL, and PTCL subtypes vary in their clinical presentation, treatment response and outcome. Historically, γδ T-ALL/LBL has been treated similar to lymphoblastic lymphoma/leukemia of other cell origin (i.e. B-ALL). However, the best induction regimen and consolidation strategy for this unique entity remains unknown. In the past the long term survival for patients diagnosed with this disease has been poor despite aggressive therapy [12]. Here we present two cases of γδ T-ALL/LBL in young adult female patients and describe their management and outcome.
Case Presentations
Case 1
Case 1 is a 26 year old pregnant female who initially presented in January 2012 at 25 weeks gestation with left shoulder pain. A routine work up performed by her obstetrician revealed a WBC count of 200,000 with 92% circulating blasts (Figure 1). She was referred to the high risk obstetrics service at this hospital and hematology was consulted for management. Peripheral blood flow cytometry was performed which was consistent with γδ T-ALL. She underwent induced vaginal delivery which was uncomplicated and was then transferred to the hematology inpatient service for treatment. Following transfer, a bone marrow aspiration and biopsy was performed that confirmed acute lymphoblastic leukemia, T-cell lineage, gamma delta subtype (Figure 2). The blasts expressed CD3, CD5 and TdT by immunohistochemistry. Flow cytometry showed that the blasts expressed CD3, gamma/delta TCR, CD2, CD5, CD10 and CD45. CT of the chest, abdomen and pelvis was performed which showed a large anterior mediastinal soft tissue mass and hepatosplenomegaly (Figure 3).
Two days following her delivery she started combination chemotherapy per the ECOG 2993 protocol which includes daunorubicin, vincristine, L-asparaginase, prednisone and intrathecal methotrexate. Initial induction was complicated by neutropenic fever that was successfully managed with empiric antibiotics. Bone marrow biopsy performed approximately 30 days after the initiation of chemotherapy did not show any evidence of residual leukemia. She continued intensification, consolidation and maintenance phases of treatment per the protocol and remained in remission until August 2012 when a repeat bone marrow biopsy demonstrated relapsed disease. She received salvage chemotherapy with FLAG-Ida and entered a second complete remission. She was then referred to the bone marrow transplant service for consideration of allogeneic stem cell transplant. No sibling donor was available and a NMDP search revealed a one antigen (A) mismatched unrelated donor. In September 2012 she received conditioning with TBI 12 Gy administered in 6 fractions over 3 days and Cyclophosphamide (CY). CY was divided into 35 mg/kg for two doses and post-transplant CY 50 mg/m2 given on day +3 along with tacrolimus and mycophenolate mofetil as a part of GVHD prophylaxis. Her immediate post-transplant course was complicated by neutropenic fever, QT prolongation felt to be medication related, diarrhea, and transient transaminitis. These toxicities resolved with appropriate management. She subsequently developed acute GVHD of the skin and gut (Stage 2 skin, stage 1 gut and overall grade 2) and was successfully treated with a steroid taper.
Her late post-transplant course was complicated by the development of transverse myelitis that is thought to be a manifestation of chronic graft versus host disease. She was successfully treated with steroids and immunosuppression. She has had intermittent idiopathic neutropenia that has responded to G-CSF administration. Chimerism studies at 1 year showed 100% CD3, 99% CD15 and 100% CD19 donor chimerism. She is currently approximately 2.5 years out from her original diagnosis and remains in complete remission.
Case 2
Case 2 is a 24 year old female who presented to an outside hospital in March of 2012 with left sided chest pain. Routine CBC was obtained which showed a WBC count of 20,100 per microliter with 46% lymphoblasts (Figure 4). A CT of the chest was performed which revealed an anterior mediastinal mass measuring 3.8 by 8.2 cm (Figure 5). There was no other lymph node enlargement and splenomegaly. She was referred to a hematologist where flow cytometry on the peripheral blood showed a T-cell lymphoproliferative process comprising 60% of the lymphocytes. She subsequently underwent bone marrow aspiration and biopsy which was suboptimal and non-diagnostic. The patient was then seen by a hematologist at this institution who referred her to thoracic surgery for a VATS procedure with biopsy. Pathology from this specimen showed T lymphoblastic lymphoma/leukemia with a high Ki-67 proliferation fraction of 95-98%. She underwent repeat bone marrow aspiration and biopsy that showed involvement by a precursor T-cell gamma-delta acute lymphoblastic leukemia with greater than 80% lymphoblasts (Figure 6). Flow cytometry from this specimen showed a population of lymphoblasts that expressed CD2, CD3, CD4, CD5, CD8, CD10 and the TCR gamma-delta (Figure 7).
Following the diagnosis the patient was started on multiagent chemotherapy per the CALGB 10403 protocol which includes vincristine, methotrexate, daunorubicin, PEG-asparaginase and prednisone. During the course of her induction she developed right eye proptosis. MRI was performed which was normal but CSF examination revealed an aberrant population of T-lymphocytes consistent with leukemic involvement. She subsequently received intrathecal cytarabine and methotrexate with clearance of the CSF. On day 30 following the initiation of induction treatment a repeat bone marrow aspiration and biopsy was performed which showed a hypocellular marrow with no morphologic evidence of leukemia. A PET scan was performed which showed a decrease in the size of the mediastinal mass with no evidence of PET avidity. Remission consolidation was then administered which included cyclophosphamide, ara-C, 6-MP, vincristine, PEG-asparaginase and IT chemotherapy. This was tolerated well without any complications. The patient was then referred to the bone marrow transplant service for consideration of allogeneic stem cell transplant. A sibling donor was assessed but was found not to be a match. A NMDP search was performed and a 10/10 HLA matched unrelated donor was identified.
Approximately 4 months following her initial diagnosis the patient received conditioning with TBI 12 Gy administered in 6 fractions over 3 days and Cyclophosphamide 35 mg/kg for two doses. Post-transplant graft-versus-host disease prophylaxis included cyclophosphamide 50 mg/m2 given on day +3 along with tacrolimus and mycophenolate mofetil started day 5. Post-transplant complications included neutropenic fever, pneumonia and acute renal failure which resolved with treatment. During her taper of tacrolimus she developed stage 1 grade 1 acute skin GVHD that was treated with topical agents. Her rash resolved and her tacrolimus taper was completed by day + 240. Bone marrow biopsy performed 3 months, 6 months and 12 months following transplant showed no evidence of recurrent leukemia. Chimerism studies showed 100% CD3 and 100% CD15 donor cells. CT scan of the chest showed complete resolution of the anterior mediastinal mass. The patient was well until approximately 18 months post-transplant when routine PFTs showed mild obstructive changes concerning for bronchiolitis obliterans. Over the subsequent 2 months she developed decreased ROM in her wrist and elbow joints bilaterally and sclerodermal skin changes consistent with chronic GVHD. Initiation of treatment with prednisone, sirolimus and Rituximab was recommended but was declined by the patient. She continues to be in complete remission from the standpoint of her leukemia with stable chronic GVHD findings.
Discussion
Few series have described the clinical course and outcome of γδ T-ALL [3]. A small series published in 1991 describes 5 cases of gamma-delta T ALL in children [15]. In this review the mean age at onset of the disease was 1.8 years compared to 5.9 years seen in other pediatric T-ALLs. All patients had marked hepatosplenomegaly which has also been described in adults with this disease. Immunophenotypically these leukemias were CD3+, CD5+, CD7+, CD4-, and CD8-. The majority were negative for TdT and CD1. The management of the patients in this series was not discussed. However, only 1 patient remained alive and in remission at the time of publication.
γδ T-ALL in the adult population has aggressive clinical course and the management was poorly described [2,3]. One series published in 2005 compared 19 cases of gamma delta T-ALL (9 children, 10 adults) with 22 cases of alpha beta T-ALL (11 children, 11 adults) [14]. In adults the majority of patients with γδ T-ALL/LBL were men (8 of 10) and only 2 presented with a mediastinal mass. This is in stark contrast to our two patients who were both female and presented with symptoms attributable to a mediastinal mass. OS survival at 5 years in this series was comparable between the gamma delta and alpha beta group (50% vs. 55%, p = 1.000). Treatment strategies however were not discussed.
A third review published in 2002 does describe the treatment and outcome of five adult patients with γδ T-ALL/LBL [12]. All patients received multiagent induction chemotherapy that usually includecombination of vincristine, cyclophosphamide, doxorubicin, methotrexate and L-asparaginase with or without prednisolone. Four out of the five patients achieved an initial complete response. One patient went on to receive an allogeneic SCT and two patients received an autologous SCT. No patients in this series were alive beyond 5 years and all had relapsed. Those who received a transplant relapsed at 16 (allo), 38 (auto) and 10 (auto) months after transplant and died 29, 60 and 14 months after initial diagnosis, respectively. The two that did not receive a transplant both lived for only 9 months.
Here we have presented two cases of γδ T-ALL in young adult female patients. Complicating the fact that this is a rare disease with a lack of consensus on treatment is that one of these patients presented in the third trimester of pregnancy. Both patients received induction chemotherapy with standard ALL regimens that included vinca alkaloids, anthracyclines, asparaginase and steroids. Consistent with previous reports, the response to induction chemotherapy was good with both patients entering a complete remission. Despite an initial response, the patient that did not undergo upfront allogeneic stem cell transplant experienced relapse within 8 months of initial treatment. In this patient a second remission was attained with salvage treatment and both patients now remain in complete remission following allogeneic unrelated stem cell transplant.
In conclusion, the rarity of γδ T-ALL makes prospective studies evaluating the efficacy of various treatment strategies difficult. Treatment recommendations must therefore be garnered through anecdotal reports and small retrospective series. Recent data suggested that it may be prudent to have genetic characterization of the disease along with assessment of minimal residual disease (MRD) in bone marrow to identify the patients with possible good outcomes when treated with pediatric protocols [14]. Another study from Germany demonstrated that patients with poor MRD response has relatively more benefit from allogeneic transplant in first complete remission (CR) when compared to those with good MRD response [15]. However, there is paucity of this data applicable to the small subset of γδ T-ALL patients. Therefore it is likely that newer treatment regimens used along with the analysis of MRD may improve outcome of T-ALL in general including this subset, and will better clarify which patients could benefit from an allogeneic SCT frontline. Based on a review of the literature as well as our own experience administering standard ALL regimen to induce the remission, followed by upfront allogeneic transplantation to eradicate potential residual disease by graft versus tumor effect can be considered in eligible patient to improve the likelihood that long term disease control.
Ayman SaaD MD; Donna Salzman MD; Raquel Innis-Shelton MD; Bone Marrow Transplantation Department, UAB
Consent
All persons gave their informed consent prior to their inclusion in the study.
- Tripodo C, Iannitto E, Florena AM, Pucillo CE, Piccaluga PP, et al. (2009) Gamma-delta T-cell lymphomas. Nat Rev Clin Oncol 6: 707-717. Link: https://goo.gl/Jqgm74
- Silva-Santos B, Serre K, Norell H (2015) [gamma][delta] T cells in cancer. Nat Rev Immunol 15: 683-691. Link: https://goo.gl/YoK4Hr
- Dallas MH, Thomas P, Choi J, Evans WE, Inaba H, et al. (2015) High Incidence of Induction Failure and Poor Outcome in Patients with Gamma Delta T Cell Acute Lymphoblastic Leukemia. Blood 126: 1421. Link: https://goo.gl/0arNf9
- Haskins K, Kubo R, White J, Pigeon M, Kappler J, et al. (1983) The major histocompatibility complex-restricted antigen receptor on T cells. I. Isolation with a monoclonal antibody. J Exp Med 157: 1149-1169. Link: https://goo.gl/rH9VSC
- Meuer SC, Fitzgerald KA, Hussey RE, Hodgdon JC, Schlossman SF, et al. (1983) Clonotypic structures involved in antigen-specific human T cell function. Relationship to the T3 molecular complex. J Exp Med 157: 705-719. Link: https://goo.gl/AL9Jat
- Bank I, DePinho RA, Brenner MB, Cassimeris J, Alt FW, et al. (1986) A functional T3 molecule associated with a novel heterodimer on the surface of immature human thymocytes. Nature 322: 179-181. Link: https://goo.gl/IbJczP
- Brenner MB, McLean J, Dialynas DP, Strominger JL, Smith JA, et al. (1986) Identification of a putative second T-cell receptor. Nature 322: 145-149. Link: https://goo.gl/W7rXZj
- de Villartay JP, Pullman AB, Andrade R, Tschachler E, Colamenici O, et al. (1989) Gamma/delta lineage relationship within a consecutive series of human precursor T-cell neoplasms. Blood 74: 2508-2518. Link: https://goo.gl/Z2NyIm
- Picker LJ, Brenner MB, Michie S, Warnke RA (1988) Expression of T cell receptor delta chains in benign and malignant T lineage lymphoproliferations. Am J Pathol 132: 401-405. Link: https://goo.gl/6RpHi6
- Groh V, Porcelli S, Fabbi M, Lanier LL, Picker LJ, et al. (1989) Human lymphocytes bearing T cell receptor gamma/delta are phenotypically diverse and evenly distributed throughout the lymphoid system. J Exp Med 169: 1277-1294. Link: https://goo.gl/5Ievzg
- Gay D, Maddon P, Sekaly R, Talle MA, Godfrey M, et al. (1987) Functional interaction between human T-cell protein CD4 and the major histocompatibility complex HLA-DR antigen. Nature 328: 626-629. Link: https://goo.gl/fC04gh
- Saito T, Matsuno Y, Tanosaki R, Watanabe T, Kobayashi Y, et al. (2002) Gamma delta T-cell neoplasms: a clinicopathological study of 11 cases. Ann Oncol 13: 1792-1798. Link: https://goo.gl/RAdkWw
- van Dongen JJ, Comans-Bitter WM, Wolvers-Tettero IL, Borst J (1990) Development of human T lymphocytes and their thymus-dependency. Thymus 16: 207-234. Link: https://goo.gl/P4TUOG
- Matos DM, Rizzatti EG, Fernandes M, Buccheri V, Falcao RP (2005) Gammadelta and alphabeta T-cell acute lymphoblastic leukemia: comparison of their clinical and immunophenotypic features. Haematologica 90: 264-266. Link: https://goo.gl/0tStR8
- Alfsen GC, Beiske K, Holte H, Hovig E, Deggerdal A, et al. (1991) T-cell receptor tau delta +/CD3+4-8-T- cell acute lymphoblastic leukemias: a distinct subgroup of leukemias in children. A report of five cases. Blood 77: 2023-2030. Link: https://goo.gl/SioHN5
Article Alerts
Subscribe to our articles alerts and stay tuned.
 This work is licensed under a Creative Commons Attribution 4.0 International License.
This work is licensed under a Creative Commons Attribution 4.0 International License.

Save to Mendeley
Save to Mendeley
